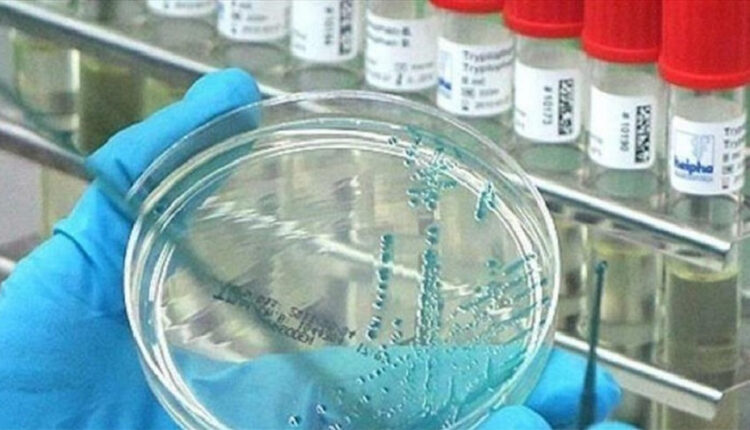

Meymunçiçəyi virusunun yeni variantı 13 ölkədə sürətlə yayılıb.
Bu barədə Ümumdünya Səhiyyə Təşkilatının məlumatında bildirilib.
Qeyd olunub ki, 14 min yoluxma və 524 ölüm halı qeydə alınıb.
ÜST virusun qarşısının alınması üçün təcili olaraq beynəlxalq müdaxilənin lazım olduğunu bəyan edib.//axar.az

Comments are closed.